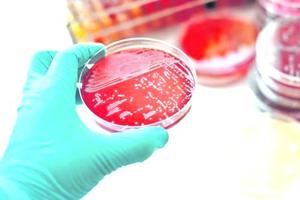

Más leídas

Actualidad | Pág. 5
Tocopilla sumó otro fallecido por covid y nueve contagios más

Actualidad | Pág. 5
Provincia registró leve descenso de casos activos en la última semana

Estrellas | Pág. 19
Desarrollan una noble acción a beneficio de vecina tocopillana

Estrellas | Pág. 19
Inauguran una plaza con juegos infantiles en localidad de Quillagua

Actualidad | Pág. 2
Positividad regional anota su mejor índice en dos meses
Pasatiempos | Pág. 17
el oráculo

Actualidad | Pág. 8
Formalizan a mujer por agresión que dejó un joven muerto y a su pareja herida

Actualidad | Pág. 8
Desalojan cerca de 80 lotes de incipiente toma

Actualidad | Pág. 8
Can detector dejó al descubierto tráfico de $465 millones en droga

Actualidad | Pág. 6
Verifican el funcionamiento de "Locales Conectados" en la pampa

Actualidad | Pág. 6
Ormitoc solicita aprobación de iniciativa para mejorar el barrio industrial de Tocopilla

Actualidad | Pág. 9
Foto denuncia: Actitud irresponsable
Actualidad | Pág. 9
Cartas

Actualidad | Pág. 9
foto DESTACADA

Actualidad | Pág. 4
Ojo los crónicos de 16 a 45 años, porque desde el lunes ya pueden comenzar a recibir la primera dosis de la vacuna

Actualidad | Pág. 4
Cifras vacunación regional

Deportes | Pág. 12
Guarachi clasificó a semis en el WTA 1000 de Dubai

Deportes | Pág. 12
Pellegrini sobrepasa la marca de Johan Cruyff

Deportes | Pág. 12
Morning golea y avanza a cuartos en Libertadores

Servicios | Pág. 14
¿Cómo la pandemia ha obligado a replantearse los hitos vitales?

Servicios | Pág. 14
Investigadores de la Universidad de Cambridge advierten sobre aumento de casos de difteria

Servicios | Pág. 14
Casi 1 de cada 3 mujeres ha sufrido violencia física o sexual

Deportes | Pág. 11
Diego Sánchez y momento de Carlos Palacios: "Es un crack"

Deportes | Pág. 11
Vidal entra al quirófano para operarse su rodilla izquierda

Deportes | Pág. 11
Mark González se recupera de un infarto agudo al miocardio
Actualidad | Pág. 3
218 nuevos casos

Actualidad | Pág. 3
Dos caras en la región: baja la velocidad de contagio pero la ocupación de camas sigue crítica

Deportes | Pág. 13
El COI anunció vacunas para todos los atletas de Tokio 2021

Deportes | Pág. 13
Gremio dio un gran paso a la otra fase de la Libertadores

Deportes | Pág. 13
La fórmula de Milad para destrabar el paro

Deportes | Pág. 13
Sorpresiva eliminación de Federer
Actualidad | Pág. 7
chile monitorea freno a oxford

Actualidad | Pág. 7
Gobierno endurece normas sanitarias tras superar los 30 mil casos activos

Deportes | Pág. 10
"Chiquito" Escalante: "El equipo que sea más regular será el que ascienda"

Deportes | Pág. 10
Concejo municipal inyecta recursos al Complejo Angamos

Estrellas | Pág. 18
Relanzan libro de destacadas científicas de la región

Estrellas | Pág. 18
Sigue el llamado a postular a becas artísticas en Antofagasta

Contraportada | Pág. 20
A los adultos mayores